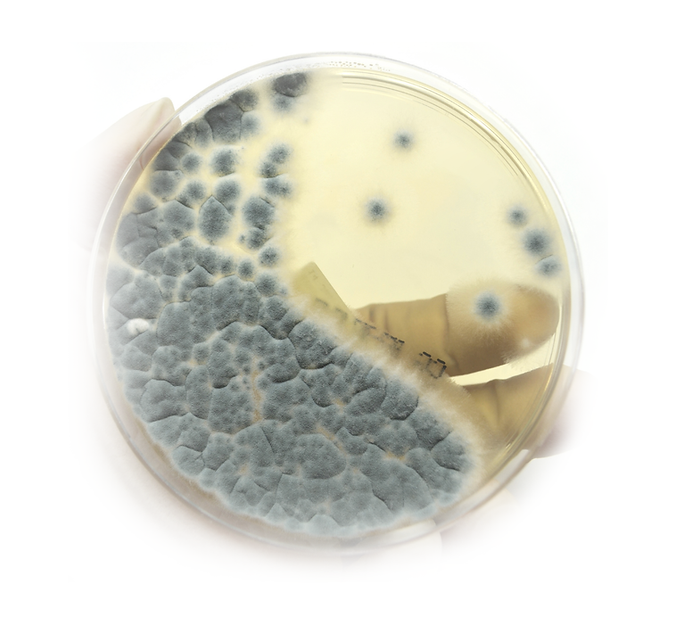

AWAAB'S LAW
With Awaab’s Law coming into effect later this year, landlords, housing associations, and local authorities face new legal responsibilities to respond quickly and effectively to damp and mould in their properties. By getting ahead of these requirements now, housing providers can demonstrate a clear commitment to tenant safety while avoiding the last-minute rush to comply.
Early adoption of proven solutions such as G21 anti-mould paint provides a straightforward and effective way to safeguard residents, ensuring healthier homes and peace of mind for both tenants and landlords.